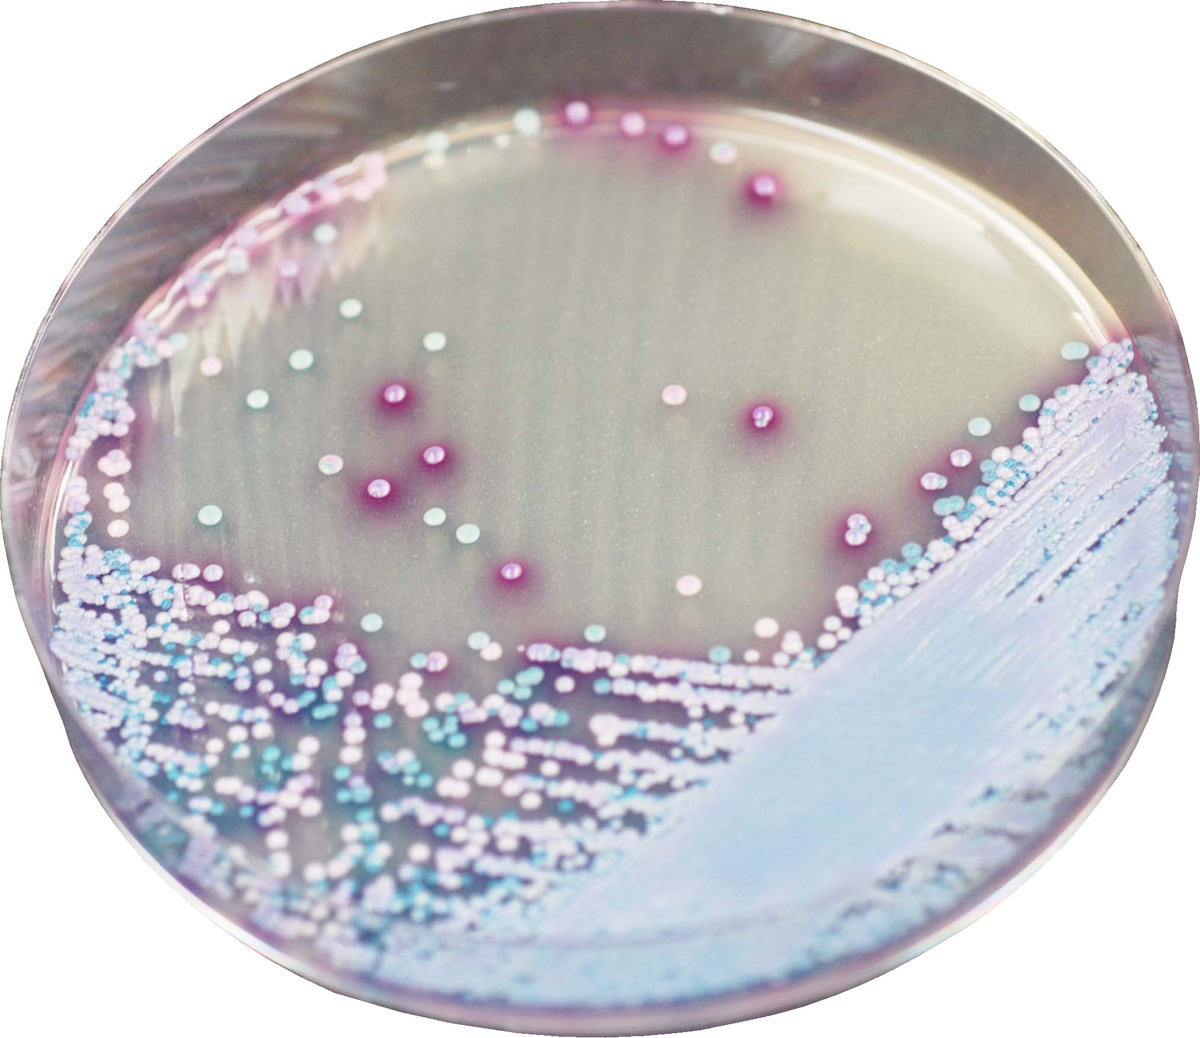
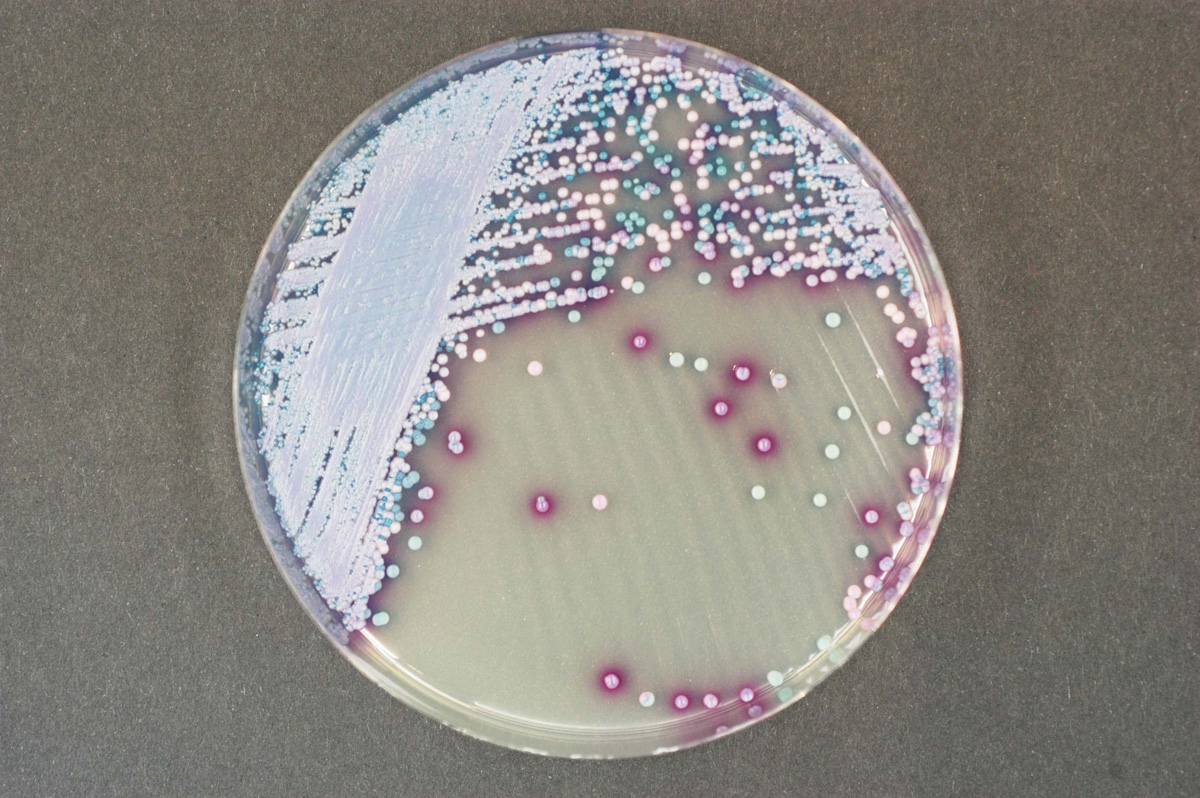

À propos du produit
Milieu chromogène pour la détection des espèces Malassezia. Le Chloramphénicol inhibe la croissance de la plupart des bactéries.
CHROMAGAR MALASSEZIA

Milieu chromogène pour la détection des espèces Malassezia. Le Chloramphénicol inhibe la croissance de la plupart des bactéries.